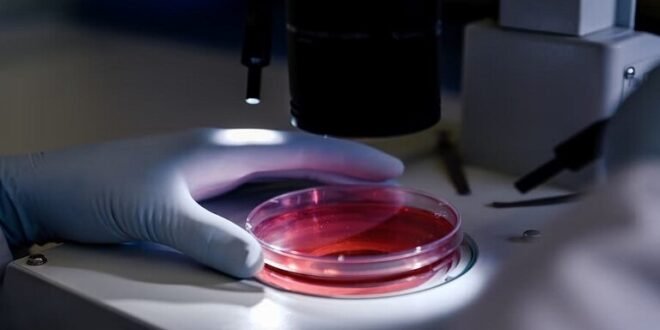

منبر العراق الحر :
تمكن متخصصون من مركز كراسنويارسك العلمي التابع لفرع أكاديمية العلوم الروسية في سيبريا، ضمن مجموعة علمية دولية، من تركيب بلورات واعدة لعلاج أمراض التنكس العصبي.
وتشير مجلة “العلم في سيبيريا” إلى أن الباحثين حصلوا على هذه البلورات من مادة هجينة جديدة، يمكن على أساسها إنتاج أدوية لعلاج أمراض ألزهايمر وباركنسون والفصام.
وقد حصل الباحثون على هذه البلورات خلال الجهود المبذولة للعثور على مواد هجينة جديدة تكون مستقرة وفعالة كمواد وأدوية نشطة بيولوجيا. واتضح لهم أن للمادة الجديدة، التي تعتمد على مركب عضوي يتكون من عدة مواد، إمكانات دوائية عالية.
ويقول يوري ماليار كبير الباحثين في معهد الكيمياء والتكنولوجيا الكيميائية: “إن الفهم الدقيق والمتعمق للتفاعلات المعقدة المحتملة بين الجزيئات والنشاط البيولوجي لهذا المثبط مهم جدا لابتكار أدوية جديدة. وتسلط هذه الدراسة الضوء على الخصائص الفيزيائية والكيميائية والبيولوجية للمادة الجديدة وتؤكد إمكانية استخدامها في علاج أمراض التنكس العصبي، مثل مرض ألزهايمر ومرض باركنسون والفصام”.
ووفقا للمجلة، تفتح هذه المادة الطريق إلى ابتكار مواد هجينة لها خصائص فريدة يمكن استخدامها في مجال الطب البيولوجي وكذلك في مجالات الطاقة والإلكترونيات.
المصدر: تاس
 منبر العراق الحر منبر العراق الحر
منبر العراق الحر منبر العراق الحر